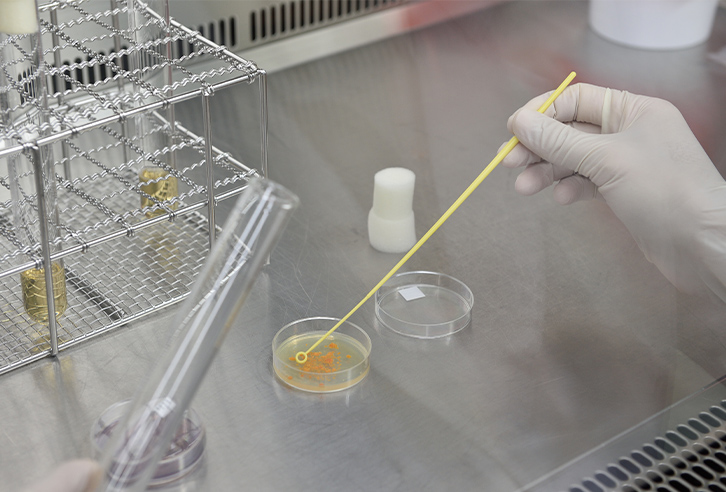

Media kit
This page provides images of the business activities of Kirin Holdings Company, Limited and Kirin Group companies (hereinafter referred to as the "The Kirin Group") for the use of media organizations (use by anyone other than media organizations is strictly prohibited).
The Kirin Group grants permission to media organizations to use the images provided on this page, provided that the media organizations comply with the following conditions. The use of images by any means other than those specified in " Terms and Conditions for Media Kit" is prohibited. Please read the terms and conditions carefully before downloading any images.
For inquiries from the media and press, please refer to "Media and Press Inquiries"
Terms and Conditions Media Contacts
Terms of use for Media Kit Content
- The copyright and other rights to the images on this page are held by the Kirin Group.
- The images on this page are the copyrighted property of the Kirin Group and may be used (reproduced, uploaded, or posted) only by media organizations for the purpose of introducing the Kirin Group and its products. Any other use of the images is prohibited without the prior written permission of the Kirin Group.
- Alteration of images is prohibited.
- When using the images, please follow the prohibitions as listed in the Terms of Use of Media Kit Content.
- The Kirin Group shall not be held liable nor bear any responsibility for any damages that may arise from the use of the images.
- The Kirin Group reserves the right to change the content of this page and the terms and conditions for the use of images without prior notice.
Food & Beverages domain
Related images of Food & Beverages domain
-

Kirin Brewery Yokohama
-

Kirin Brewery Brewing Facilities
-

Kirin Brewery Brewing Facilities(February 2020)
-

Spring Valley Brewery Tokyo
-

Kirin Fuji Gotemba Distillery
-

Kirin Fuji Gotemba Distillery
-

Kirin Beverage Shonan Factory
-

Kirin Beverage Vending Machine
-

Chateau Mercian Katsunuma Winery
-

Chateau Mercian Mariko Winery
-

Chateau Mercian Kikyogahara Winery
-

Lion(Australia) XXXX Brewery
-

Coca Cola Beverages Northeast(United States) Londonderry Sales Center
Health Science domain
Related images of Health Science domain
Pharmaceuticals domain
Related images of Pharmaceuticals domain